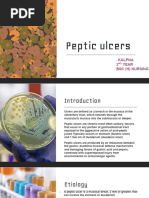

100% found this document useful (2 votes)
3K views78 pagesACLS
ACLS is a set of clinical guidelines for treating life-threatening cardiovascular conditions. It aims to restore normal circulation and breathing through interventions like chest compressions, airway management, ventilation, defibrillation, and drugs. ACLS follows algorithms to evaluate patients and provide the indicated treatments.
Uploaded by
KajalCopyright
© © All Rights Reserved
We take content rights seriously. If you suspect this is your content, claim it here.
Available Formats
Download as PPTX, PDF, TXT or read online on Scribd
100% found this document useful (2 votes)
3K views78 pagesACLS
ACLS is a set of clinical guidelines for treating life-threatening cardiovascular conditions. It aims to restore normal circulation and breathing through interventions like chest compressions, airway management, ventilation, defibrillation, and drugs. ACLS follows algorithms to evaluate patients and provide the indicated treatments.
Uploaded by
KajalCopyright
© © All Rights Reserved
We take content rights seriously. If you suspect this is your content, claim it here.
Available Formats
Download as PPTX, PDF, TXT or read online on Scribd
- Title Page
- Introduction
- Definition
- Purpose of ACLS
- Indications of ACLS
- Contraindications
- Chain of Survival
- Systematic Approach
- BLS Assessment
- What is CPR?
- CPR Procedures
- Advanced Cardiac Life Support
- Drugs Used in ACLS
- Treatable Causes of Cardiac Arrest
- When to Stop CPR
- Post Resuscitation Care
- Nursing Responsibilities During ACLS
- Conclusion